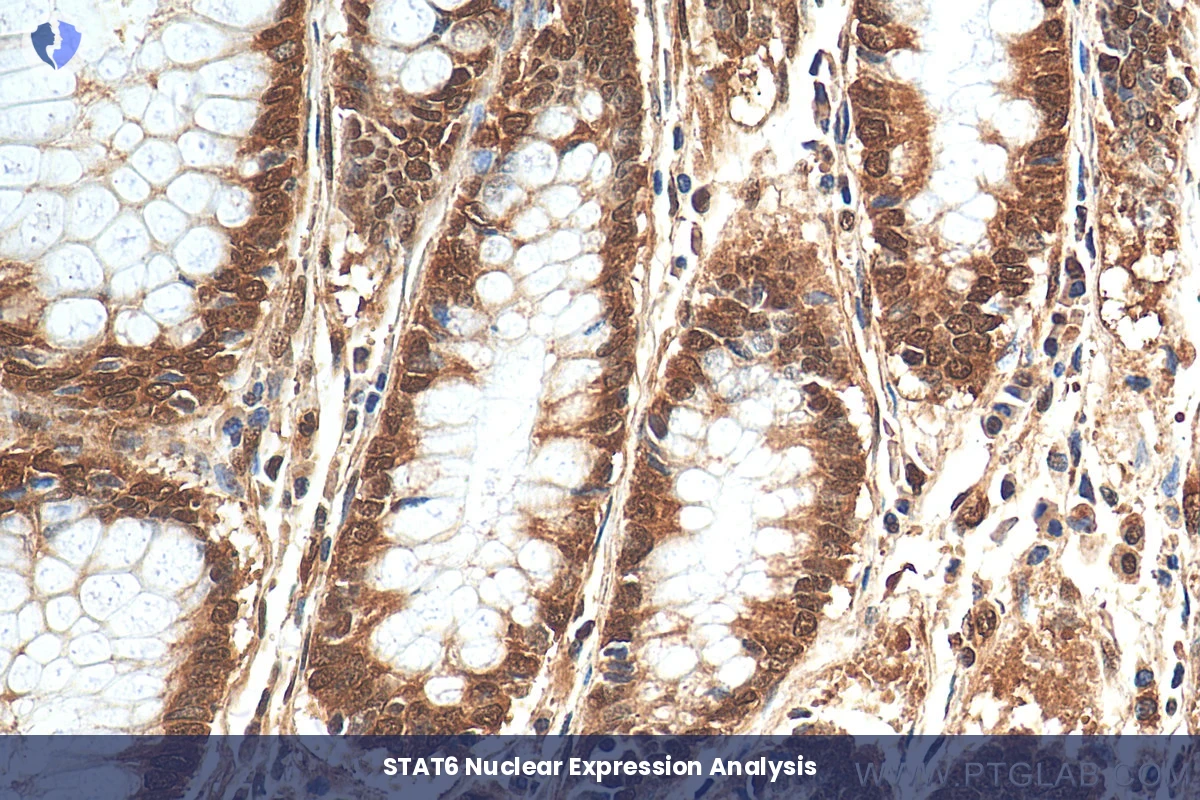
Solitary Fibrous Tumor Diagnosis - Immunohistochemistry (IHC) for STAT6

Service Details
Solitary Fibrous Tumor Diagnosis - Immunohistochemistry (IHC) for STAT6
Immunohistochemical (IHC) testing detects the nuclear expression of STAT6 (Signal Transducer and Activator of Transcription 6), particularly that resulting from the specific gene fusion NAB2-STAT6. This fusion is the characteristic gene mutation underlying the majority of solitary fibrous tumors (SFTs). Nuclear STAT6 expression is a highly sensitive and specific diagnostic marker for SFT, superior to traditional markers such as CD34 and BCL-2.